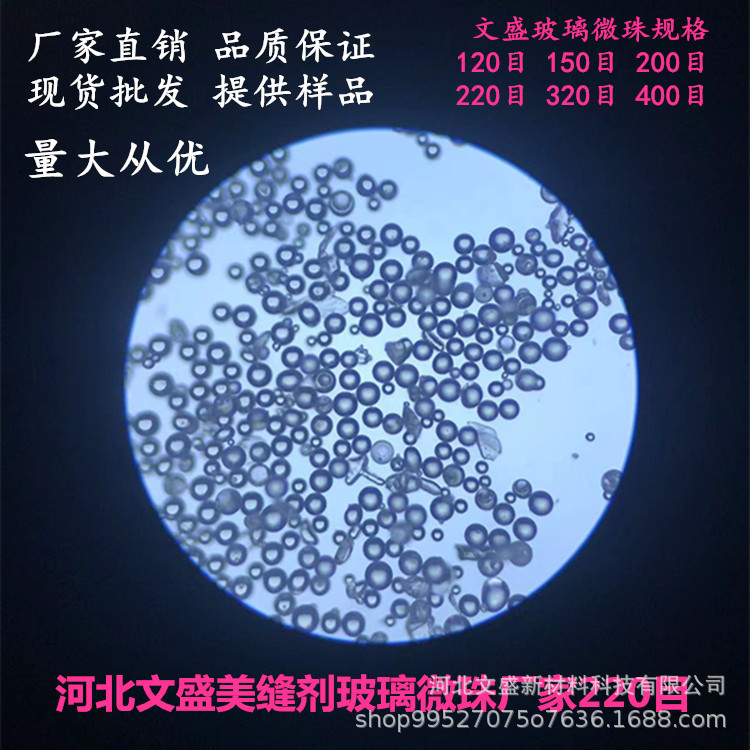
80-100目实心喷砂珠模具行业型腔清理圆度模具表面喷砂处理

-
美甲底胶封层套装美甲店专用专业免洗钢化玻璃封层甲油胶功能胶
-
儿童超轻新款硅胶防滑运动学生专业配有度数离焦抗疲劳近视眼镜架
-
舒尔美迷你修眉刀新手专业化妆修眉工具不锈钢刀片刮眉刀工厂批发
-
超轻儿童近视眼镜框学院风素颜青少年离焦防控眼镜架专业网上配镜
-
超轻TR防蓝光近视眼镜专业配镜男女方框防辐射电脑手机时尚平光镜
-
超轻儿童近视眼镜框防控离焦镜片专用青少年眼镜架专业网上配镜
-
超轻儿童近视眼镜框硅胶防滑防控离焦镜片专用青少年镜框专业配镜
-
儿童超轻纯钛近视眼镜框学院风青少年离焦近视眼镜框专业网上配镜
-
专业儿童防控近视眼镜框可调节鼻托无螺丝青少年TR镜框批发T046ET
-
新款太阳墨镜户外专业骑行眼镜防晒防紫外线男女款运动连体太阳镜